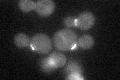

View description
Targeting subunit for Glc7p protein phosphatase, localized to the bud neck, required for localization of chitin synthase III to the bud neck via interaction with the chitin synthase III regulatory subunit Skt5p
Localization:
Intensity:
Fold change:
Significance:
-
C’ GFP library in SD
bud neckN/A -
N' NOP1pr-GFP in SD

bud neck63.6476 -
N' TEF2pr-mCherry in SD

missing0 -
N' NATIVEpr-GFP in SD

bud neck29.473 -
N' TEF2pr-VC and Cyto-VN in SD

#N/A0 -
C’ GFP library in SD+DTT

bud neck25.261.01No -
C’ GFP library in SD+H2O2

bud neck20.750.83No -
C’ GFP library in Starvation Media

cytosol20.160.81No -
C’ GFP library on the background of Pup2-DaMP

bud neck -
C’ GFP library on the background of CCT mutant

bud neck22.82020.918339No
